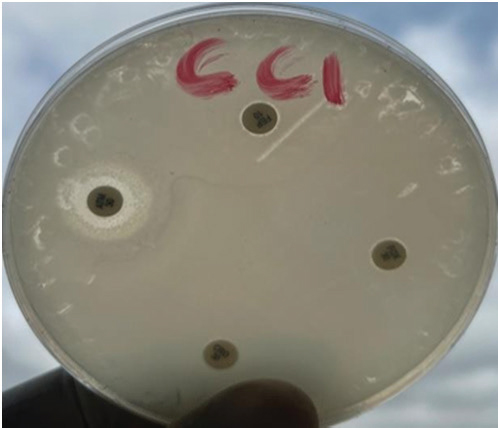

| Research Article | ||
Open Vet. J.. 2025; 15(4): 1615-1623 Open Veterinary Journal, (2025), Vol. 15(4): 1615-1623 Research Article Distribution of cephalosporin-resistant Campylobacter species isolated from meat sold in Abakaliki, NigeriaNnabuife Bernard Agumah1, Mustofa Helmi Effendi2, Wiwiek Tyasningsih3*, Adiana Mutamsari Witaningrum2, Emmanuel Nnabuike Ugbo1, Onyinyechi Blessing Agumah1, Riza Zainuddin Ahmad4, Chinekwu Sherridan Nwagwu5, Agatha Ifunanya Ugbo6, Aswin Rafif Khairullah4, Ikechukwu Benjamin Moses1, Sheila Marty Yanestria7, Katty Hendriana Priscilia Riwu8, and Wasito Wasito41Department of Applied Microbiology, Faculty of Science, Ebonyi State University, Abakaliki, Nigeria 2Division of Veterinary Public Health, Faculty of Veterinary Medicine, Universitas Airlangga, Surabaya, Indonesia 3Division of Veterinary Microbiology, Faculty of Veterinary Medicine, Universitas Airlangga, Surabaya, Indonesia 4Research Center for Veterinary Science, National Research and Innovation Agency (BRIN), Bogor, Indonesia 5Department of Pharmaceutics, University of Nigeria, Nsukka, Nigeria 6Department of Microbiology and Parasitology, David Umahi Federal University of Health Sciences, Uburu, Nigeria 7Faculty of Veterinary Medicine, Universitas Wijaya Kusuma Surabaya, Surabaya, Indonesia 8Department of Veterinary Public Health, Faculty of Veterinary Medicine, Universitas Pendidikan Mandalika, Mataram, Indonesia *Corresponding Author: Wiwiek Tyasningsih. Division of Veterinary Microbiology, Faculty of Veterinary Medicine, Universitas Airlangga, Surabayas, Indonesia. Email: wiwiek-t [at] fkh.unair.ac.id Submitted: 02/12/2024 Accepted: 20/03/2025 Published: 30/04/2025 © 2025 Open Veterinary Journal
AbstractBackground: Campylobacter species have been at the forefront of the field as etiologic agents of foodborne gastroenteritis. The importance of animal proteins, especially contaminated meat, in the transmission of Campylobacteriosis cannot be overstated. Antimicrobial resistance by Campylobacter species is imminent, which underscores the importance of this study. Aim: This study aimed to determine the antibiograms of Campylobacter species isolated from various meat samples sold in Abakaliki to select Cephalosporin antibiotics. Methods: We purchased 100 samples of various meat, Chevon (25), Pork (25), Beef (25), and Chicken (25) from four different market locations in Abakaliki. Culture and bacterial isolation were aseptically performed using standard bacteriological techniques. Campylobacter isolates obtained were confirmed using standard biochemical tests. Antibiotic susceptibility was assessed using Kirby Bauer’s disc diffusion method. The selected cephalosporins used in this study included cefoxitin, ceftriazone, and cefepime. Aztreonam was used as a tangential control. Results: Our results showed that 69.0% of Campylobacter coli was isolated from this study, with chickens having the highest distribution (92.0%). The isolation percentage of Campylobacter jejuni was 55.0%, with chicken also exhibiting the highest distribution (80.0%). The Ishieke market had the highest distribution of C. coli (75.0%). The central abattoir had the highest distribution for C. jejuni (50.0%). Resistance recorded by C. coli to various antibiotics employed include; Cefoxitin (52.2%), Ceftriazone (55.1%), Cefepime (57.9%), and azatreonam (73.9%). The resistance of C. jejuni to various antibiotics employed include; Cefoxitin (45.5%), Ceftriazone (60.0%), Cefepime (63.6%), and azatreonam (56.4%). Conclusion: The distribution of cephalosporin-resistant Campylobacter is high and represents a public health concern. More caution with hygiene and the use of antibiotics in animal husbandry is highly advocated. Keywords: Campylobacter, Cephalosporins-resistant, Meats, Nigeria, Public health. IntroductionOne of the most prevalent causes of enteritis and gastroenteritis in humans, affecting both adult and pediatric patients, is the bacterium of the genus Campylobacter (Facciolã et al., 2017). In wealthy nations, the number of cases of campylobacteriosis has surpassed that of enteric bacteria. The microbe is isolated from individuals with gastrointestinal tract infections at a rate that is roughly three to four times higher than that of Salmonella or Escherichia coli (EFSA and ECDC, 2013). The data, while not very good, indicate that the rate of Campylobacter infection has recently increased in low- and middle-income areas (Platts-Mills and Kosek, 2014). Because of the irregular nature of the illness and the significant role that cross-contamination plays, it is often challenging to identify the sources of exposure to Campylobacter. Numerous farm animals (cattle and pigs), companion animals (dogs and cats), and wild animals (birds like ducks and gulls) have commensal bacteria in their gastrointestinal tracts. In addition, it is typically found in all bird species suitable for human consumption (Okunlade et al., 2015). These are the microbes that cause zoonoses, and the fecal-oral pathway is how the disease is spread by consuming tainted foods and drinks (Shen et al., 2018). The gastrointestinal tract of all avian species, especially poultry (broilers, laying hens, turkeys, ducks, and ostriches), which is thought to be the primary channel of transmission, represents the principal environmental niche (Facciolã et al., 2017). Consuming this meat actually accounts for 50%–70% of occurrences of campylobacteriosis in humans (Igwaran and Okoh, 2019). Nonetheless, consuming raw milk, raw red meat, fruits, and vegetables may also contribute to the spread of the disease (Verhoeff-Bakkenes et al., 2011; Rapp et al., 2012). Additionally, it is believed that handling or consuming raw or undercooked chicken flesh is the primary cause of campylobacteriosis (Mullner et al., 2009). The extensive use of antibiotics in poultry and livestock farming has been identified in various studies as a contributing factor to the increase in antimicrobial resistance (AMR) (Khairullah et al., 2020; Wibisono et al., 2021; Tyasningsih et al., 2022). Enrofloxacin, a fluoroquinolone antimicrobial commonly used in poultry for prophylactic or therapeutic purposes, is typically administered via drinking water, contrasting with its limited use in sick pigs and cattle (Grabowski et al., 2022). Consequently, Campylobacter strains isolated from chickens exhibit the highest levels of resistance to fluoroquinolones (Yanestria et al., 2024). This situation is particularly alarming because antibiotic-resistant bacteria from poultry can easily be transferred to humans through contaminated food or the environment, resulting in infections that are challenging to treat (Hemeg, 2018; Yanestria et al., 2022). Consuming poultry contaminated with Campylobacter jejuni, whether through eggs or meat, represents the primary cause of sporadic campylobacteriosis in humans (Cha et al., 2016). Additionally, humans can acquire infections through activities involving contact with poultry feces, such as cleaning cages, changing bedding, and handling birds, as poultry excrete C. jejuni bacteria in their droppings (Varga et al., 2019; Yanestria et al., 2023). However, it is crucial to recognize the significance of pigs and cattle, which are frequently colonized with C. jejuni and Campylobacter coli. In addition, numerous studies have demonstrated that Campylobacter is primarily found in the lower gastrointestinal tract of cattle, while it is also present in the liver, gall bladder, and bile juice (Facciolã et al., 2017). Cephalosporin-resistant enterobacterales infections are linked to unfavorable outcomes in human medicine. Controlled epidemiological analyses are not common in veterinary medicine (Shnaiderman-Torban et al., 2021). Globally, enterobacterales resistant to cephalosporins are proliferating (Singh et al., 2019). The generation of plasmid-mediated extended-spectrum β-lactamases and AmpC β-lactamases, along with the overproduction of chromosomal Amp-C β-lactamases, are the primary causes of resistance (Lee et al., 2012). Cephalosporins are classified by the World Organization for Animal Health as critically important veterinary antimicrobials (WHO, 2021). Nonetheless, there have been more and more reports in recent years about animal colonization and illnesses caused by cephalosporin-resistant Enterobacteriaceae (Walther et al., 2017). Therefore, this research aimed to detect cephalosporin-resistant Campylobacter species isolated from various meats sold in Abakaliki, Nigeria. Materials and MethodsStudy areaThe study area is Abakaliki, the capital city of Ebonyi. The major areas in Abakaliki where meat samples were purchased included the International Market Abattoir, Central Market (Gariki), Ishieke Market, and Kpiri-Kpiri Market. Sample collectionOne hundred samples (25 each) samples of various animal proteins were collected for this study. The samples included beef, goat meat, pork, and chicken. These proteins were purchased from various outlets in Abakaliki and used in the study. In terms of location, 25 samples were collected from International Market and Kpiri-Kpiri. Thirty samples were collected from Central Abattoir (Garki) and 20 were collected from Ishieke Market. Isolation and identification of Campylobacter speciesFrom the examined samples, Campylobacter species were isolated, as recently reported by Ghoneim et al. (2020) and Agumah et al. (2024). In summary, sterile thioglycollate broth was used to homogenize 10 g of each meat sample. Subsequently, the broth samples were incubated in a microaerophilic environment for 48 42°C. Modified charcoal cefaperaxone deoxycholate agar plates (Oxoid) were streaked with a loopful of enrichment broth, and the plates were then incubated for 48 42°C in a microaerophilic environment. The colonies will then be examined under a microscope to determine the species of Campylobacter. Suspected Campylobacter colonies were subcultured one or more times on 5% sheep blood agar until monocultures were achieved. On MacConkey agar, colonies were also subcultured. Additional tests for the identification of Campylobacter species included biochemical analyses using gram staining, oxidase, catalase, hippurate hydrolysis, nitrate reduction, and H2S generation in triple-sugar iron media. Antimicrobial susceptibility testThis investigation employed the Kirby-Bauer disk diffusion method using Mueller-Hinton agar (Liofilchem, Italy) enriched with 5% sheep blood (Effendi et al., 2022; Ugbo et al., 2023). After inoculating the plates with 0.5 Mcfarland suspension, they were microaerophilically incubated for 24 48°C (CLSI, 2020). The following medications were examined; they were obtained from OXOID (UK): ceftazidime, cefotaxime, ceftriaxone, cefoperazone, and cefsulodin. The interpretation of inhibition zones was based on the CLSI (2020) breakpoints for Campylobacter. Ethical approvalNot needed for this study. ResultOur findings show that two Campylobacter species were isolated from meat samples employed in this study. The two species include; C. coli and C. jejuni (Tables 1 and 2). Results demonstrate that the total percentage of isolates for C. coli was 69.0%, with chicken accounting for the highest (92.0%), and pork accounting for the lowest (48.0%) rates, respectively. A total isolation percentage of 55.0% was recorded for C. jejuni, with chicken and beef accounting for the highest (80.0%) and lowest (36.0%), respectively. With respect to location, the highest distribution (75.0%) of C. coli was recorded in meat samples purchased from Ishieke Market, whereas the lowest (36.0%) was recorded in meat samples obtained from Kpiri-kpiri. The highest distribution (50.0%) of C. jejuni was reported in meat samples purchased from the Central Abattoir, whereas the lowest (32.0%) was recorded in meat samples acquired from the International market (Tables 3 and 4). Table 1. Distribution of Campylobacter coli isolated from meat sold in Abakaliki, Turkey.
Table 2. Distribution of Campylobacter jejuni isolated from meat sold in Abakaliki, Turkey.
Table 3. Distribution of Campylobacter coli isolates from meat sold in Abakaliki according to location.
Table 4. Distribution of Campylobacter jejuni isolated from meat sold in Abakaliki according to location.
Cefoxitin (a second-generation cephalosporin) was resisted by 52.2% (36) of the total C. coli isolates, whereas 47.8% (33) were susceptible (Table 5). The highest resistance was recorded for C. coli isolated from chickens (60.9%), whereas the lowest resistance (33.3%) was recorded for isolates obtained from pork. It was also resisted by 45.5% (25) of the total C. jejuni strains, and 54.5% (30) were susceptible. The highest resistance was recorded for C. jejuni isolated from pork (46.7%), whereas the lowest resistance (44.4%) was recorded for isolates obtained from beef. Ceftriaxone (a third-generation cephalosporin) was resisted by 55.1% (38) of the total C. coli isolates, whereas 44.9% (31) were susceptible (Table 6). The highest resistance (78.3%) was observed for C. coli isolates from chicken, whereas the lowest resistance (41.7%) was observed for isolates obtained from pork. Similarly, 60.0% (33) of the total C. jejuni isolates were resistant to ceftriaxone, whereas 40.0% (22) were susceptible. The highest resistance to C. jejuni was recorded in isolates from chevon (81.8%), and the lowest resistance (33.3%) was observed in isolates from beef. Cefepime (a fourth-generation cephalosporin) was resisted by 57.9% (40) of the total C. coli isolates, and 42.0% (29) were susceptible (Table 7). The highest resistance was recorded from C. coli isolated from pork (75.0%), and the lowest resistance (43.8%) was recorded from isolates obtained from Beef. Cefepime was also resisted by 63.6% (35) of the total C. jejuni isolates, and 36.4% (20) were susceptible. The highest resistance was recorded for C. jejuni isolated from chickens (70.0%). The lowest resistance (43.8%) was recorded for isolates obtained from beef. Aztreonam (a macrolide) was resisted by 73.9% (51) of the total C. coli isolates, and 26.1% (18) were susceptible (Table 8). The highest resistance was recorded for C. coli isolated from chickens (86.9%) (Fig. 1), and the lowest resistance (58.3%) was recorded from isolates obtained from pork (Fig. 3). It was also resisted by 56.4% (31) of the total C. jejuni that were isolated and 43.6% (24) were susceptible. The highest resistance was recorded for C. jejuni isolated from chevon (72.7%) (Fig. 2), whereas beef recorded the lowest resistance. DiscussionFindings from our study agree with various investigations that have been carried out, especially regarding the primary isolation of Campylobacter species from different animal protein sources (meat); however, specific indices are in disagreement. In contrast to our study, Poudel et al. (2022) reported that C. jejuni was most prevalent (25.4%) in poultry meat samples. Another study that assessed the incidence of Campylobacter in poultry meat in Estonia, Latvia, and Lithuania also reported C. jejuni as the most prevalent (75%) (Tedersoo et al., 2022). Debelo et al. (2022) reported C. jejuni as the most prevalent (23.7%) in a study evaluating the incidence of Campylobacter in a cattle abattoir in Ethiopia. Another study in Canada on the epidemiology of AMR Campylobacter spp. isolated from retail meats reported that C. jejuni was more prevalent (94.6%) than C. coli (5.4%) in poultry, with pork and beef samples being completely negative. Table 5. Antibiotic susceptibility of Campylobacter species isolated from meat sold in Abakaliki to Cefoxitin (FOX; 30 μg) (second generation cephalosporin),
Table 6. Antibiotic susceptibility of Campylobacter species isolated from meat sold in Abakaliki to Ceftriazone (CEF; 30 μg) (third generation cephalosporin).
Table 7. Antibiotic susceptibility of Campylobacter species isolated from meat sold in Abakaliki–cefepime (FEP; 10 μg)
Table 8. Antibiotic susceptibility of Campylobacter species isolated from meat sold in Abakaliki to Aztreonam (ATM; 30 μg) (Monobactam).generation cephalosporin).
Fig. 1. Susceptibility reaction of Campylobacter isolates from chickens on Mueller Hinton's agar. On this plate, the Campylobacter isolate was subtly inhibited by Aztreonam as shown by the clear zone. The isolates resisted cefepime, Ceftriazone, and cefoxitin.
Fig. 2. Susceptibility of Campylobacter isolates from Chevon on Mueller Hinton's agar. On this plate, the Campylobacter isolate was inhibited by Aztreonam and Ceftriazone as shown by the clear zones. The isolate resisted Cefepime and Cefoxitine. The most significant reservoir for human campylobacter species infection in Nigeria, according to Benshak et al. (2023), is thought to be wild birds (38%), followed by chickens (23%), pigs (19%), and cattle (11%). Braide et al. (2017), in a study in Owerri, reported C. coli to be more prevalent (34%) than C. jejuni (12.5%) in beef. A study in Congo reported a prevalence of 34.6% for the isolation of Campylobacter species from goats and retail goat meat, with C. coli being the most predominant (26.7%) and C. coli being the least predominant (10.1%). Findings from our study also show that most of the Campylobacter isolates were from poultry meat (chicken). Food animals such as pigs, cattle, and poultry (chicken and turkey) frequently present with Campylobacter in their gastrointestinal tracts (Wieczorek and Osek, 2015). Because poultry has a physiological temperature of 42°C and Campylobacter proliferates most at 42°C, poultry provides the best growing environment for bacteria (Horrocks et al., 2009). As a result, Campylobacter is far more abundant in the gastrointestinal tract of chickens and serves as their ultimate host. Worldwide, C. jejuni and C. coli are acknowledged as the most frequent causes of bacterial gastroenteritis. Antibiotic-resistant Campylobacter has emerged in recent years, particularly against first-choice medications for campylobacteriosis (Portes et al., 2023). It is impossible to overstate the significance of AMR, particularly in animal isolates, because it poses a major risk to veterinary and medical care. Another important reason for this is the significantly greater difficulty of campylobacter zoonotic transmission. Campylobacter has a strong potential for developing resistance to traditional antibiotics.
Fig. 3. Susceptibility of Campylobacter isolates from pork on Mueller Hinton's agar. On this plate, the Campylobacter isolate was inhibited by Aztreonam, Ceftriazone, and cefoxitine, as indicated by the clear zones. The isolateresisted cefepime. Because campylobacteriosis is a zoonotic foodborne illness, human infections are also affected by the existence of resistant strains in the food chain. The use of these antimicrobial drugs in animal production is one of the primary reasons promoting AMR, particularly to fluoroquinolones and macrolides (Wieczorek and Osek, 2013). The widespread use of antibiotics in animal husbandry is frequently attributed to the rise in antibiotic resistance among bacterial populations (Effendi et al., 2018). Campylobacter has evolved several antibiotic resistance mechanisms to withstand the selection pressure imposed by the use of antibiotics in both veterinary and human medicine (Gahamanyi et al., 2020; Kate et al., 2020). These mechanisms include changing or mutating the targets of antibiotics, changing, or inactivating antibiotics, and decreasing drug accumulation through the action of drug efflux pumps (Mpalang et al., 2014; Narvaez-Bravo et al., 2017). While some of these processes lead to multidrug resistance, others result in resistance to a particular class of antimicrobials (Wang et al., 2017). For human Campylobacter infections, supportive antimicrobial therapies are typically not necessary; still, immunocompromised people, such as patients with predisposing diseases, expectant mothers, young children, and the elderly, may need antibiotic therapy. In these cases, the most commonly administered medications for human campylobacteriosis include aminoglycosides, macrolides (such as erythromycin and azithromycin), and fluoroquinolones (such as ciprofloxacin) (Dai et al., 2020). Various studies have reported resistance to conventional antibiotics by Campylobacter species (Modi et al., 2015; Premarathne et al., 2017; Agumah et al., 2024; Yanestria et al., 2024). Cephalosporins, which appear to be higher and more effective with a spectrum of activity than most conventional antibiotics, are expected to relieve very profuse Campylobacteriosis, similar to other bacterial infections. The mechanisms underlying Campylobacter resistance to certain expanded-spectrum cephalosporins and betalactam, such as ampicillin, are varied and poorly understood (Wieczorek and Osek, 2013). Most Campylobacter strains are generally thought to be resistant to betalactam antimicrobial drugs, particularly penicillins and narrow-spectrum cephalosporins, with the exception of a few carbapenems. Findings from our study revealed resistance to selected cephalosporins spread across three generations, with aztreonam (a macrolide) acting as a conventional antibiotic and tangential control. Resistance recorded for isolates from all meat samples from our study indicates that Campylobacter could be building resistance against the highly effective cephalosporin class of antibiotics. The indiscriminate use of antibiotics by animal farmers in Nigeria and most countries, especially in Sub-Saharan Africa, is still at an alarming rate. Antimicrobial therapy and infection prevention continue to be heavily utilized in poultry, which has led to the transmission of resistant strains to people (Elhadidy et al., 2018). Nonetheless, some nations are exhibiting encouraging patterns. For instance, Scandinavian nations often have low levels of antimicrobial use in their poultry. Carbapenems, fluoroquinolones, colistin, and third- and fourth-generation cephalosporins have all been designated as “critically important” by Denmark, and usage of these antibiotics is now limited. In Denmark, the chicken industry does not employ cephalosporins or colistin, and very few fluoroquinolones are used. Because antibiotics are rarely used, the situation in Swedish broiler production is excellent (Björkman et al., 2021). As a result, Sweden has a low prevalence of resistant bacteria isolated from animals. ConclusionIn conclusion, the incidence of AMR bacteria in meat is of utmost public health concern, especially as it has both veterinary and medical implications for humans and even animals. Our study established that Campylobacter species were isolated from all meat samples obtained with the highest frequency reported for chicken. Campylobacter jejuni and C. coli isolates from this study were all resistant to the Cephalosporin antibiotics employed in this study. Over 50% resistance was recorded for all cephalosporin antibiotics for cefoxitin, except that the zoonotic transmission of resistant bacteria into the food chain plays some role in affecting the general well-being of humans. The most common cause of bacterial gastroenteritis is Campylobacter. It poses a serious threat to human health. Although a lot of studies have been conducted to identify this causal agent, many elements of its epidemiology remain unknown. Acquiring Campylobacter data on AMR aids in educating the public about the inappropriate use of antibiotics in infectious infections. Findings from this study indicate an optimal distribution of cephalosporin-resistant Campylobacter in various meats sold in Abakaliki. More caution should be observed in the use of hygiene and antibiotics in animal husbandry. Sufficient education on appropriate cooking methods and antibiotic administration is necessary. To stop this spread, food handlers and herders should be well-versed in sanitation and proper hygiene standards. AcknowledgmentsThe authors are grateful to Universitas Airlangga. Conflict of interestThe authors declare no conflict of interest. FundingThis study was supported in part by the International Research Consortium, Lembaga Penelitian dan Pengabdian Masyarakat, Universitas Airlangga, in 2024 (grant number: 171/UN3.LPPM/PT.01.03/2024). Author’s contributionsNBA, RZA, and ENU: Conceived, designed, and coordinated the study. OBA, WW, and CSN: Designed data collection tools and supervised field sampling, data collection, laboratory work, and data entry. MHE, AMW, and WT: Validation, supervision, and formal analysis. AIU and IBM: Contributed reagents, materials, and analysis tools. ARK, KHPR, and SMY: Statistical analysis and interpretation and preparation of the manuscript. All authors have read, reviewed, and approved the final manuscript. Data availabilityAll data are available in the manuscript. ReferencesAgumah, N.B., Effendi, M.H., Witaningrum, A.M., Tyasningsih, W., Ugbo, E.N., Nwagwu, C.S. and Ugbo, I.A. 2024. Antimicrobial resistance in Campylobacter species isolated from commercially sold steak (beef) and raw cow milk in Abakaliki, Nigeria. Biodiversitas 25(3), 950–956. Benshak, J.A., Strachan, N., Lopes, B., Ramjee, M., Macrae, M. and Forbes, K. 2023. Identifying the sources of human campylobacteriosis in Nigeria. Acta Trop. 237(1), 106702. Björkman, I., Röing, M., Lewerin, S.S., Lundborg, C.S. and Eriksen, J. 2021. Animal production with restrictive use of antibiotics to contain antimicrobial resistance in Sweden” a qualitative study. Front. Vet. Sci. 15(1), 1197. Braide, W., Adeleye, S.A., Ohanusi, I., Ibegbulem, C.R., Mike-Anaosike, E.E. and Madu, L.C. 2017. Incidence of Campylobacter species in poultry products and beef sold in Owerri, Imo State, Nigeria. EC Microbiol. 10(4), 147–155. Cha, W., Mosci, R., Wengert, S.L., Singh, P., Newton, D.W., Salimnia, H., Lephart, P., Khalife, W., Mansfield, L.S., Rudrik, J.T. and Manning, S.D. 2016. Antimicrobial susceptibility profiles of human Campylobacter jejuni isolates and association with phylogenetic lineages. Front. Microbiol. 7(1), 589. CLSI (Clinical and Laboratory Standards Institute). 2020. Performance standards for antimicrobial disk diffusion susceptibility testing; 17th informational supplement. Approved standard M100-17. Wyne, PA: Clinical and Laboratory Standards Institute. Dai, L., Sahin, O., Grover, M. and Zhang, Q. 2020. New and alternative strategies for the prevention, control, and treatment of antibiotic-resistant Campylobacter. Transl. Res. 223(1), 76–88. Debelo, M., Mohammed, N., Tiruneh, A. and Tolosa, T. 2022. Isolation, identification and antibiotic resistance profile of thermophilic Campylobacter species from Bovine, Knives and personnel at Jimma Town Abattoir, Ethiopia. PLoS One 17(10), e0276625. Effendi, M.H., Faridah, H.D., Wibisono, F.M., Wibisono, F.J., Nisa, N., Fatimah, F. and Ugbo, E.N. 2022. Detection of virulence factor encoding genes on Escherichia coli isolated from broiler chicken in Blitar District, Indonesia. Biodiversitas 23(7), 3437–3442. Effendi, M.H., Oktavianto, A. and Hastutiek, P. 2018. Tetracycline resistance gene in Streptococcus agalactiae isolated from bovine subclinical mastitis in Surabaya, Indonesia. Philipp. J. Vet. Med. 55(SI), 115–120. EFSA (European Food Safety Authority) and ECDC (European Centre for Disease Prevention and Control). 2013. The European Union Summary Report on antimicrobial resistance in zoonotic and indicator bacteria from humans, animals and food in 2011. EFSA J. 11(5), 3196. Elhadidy, M., Miller, W.G., Arguello, H., ãlvarez-Ordããez, A., Duarte, A., Dierick, K. and Botteldoorn, N. 2018. Genetic basis and clonal population structure of antibiotic resistance in Campylobacter jejuni isolated from broiler carcasses in Belgium. Front. Microbiol. 9(1), 1014. Facciolã, A., Riso, R., Avventuroso, E., Visalli, G., Delia, S.A. and Laganã, P. 2017. Campylobacter: from microbiology to prevention. J. Prev. Med. Hyg. 58(2), E79–E92. Gahamanyi , N., Mboera, L.E.G., Matee, M.I., Mutangana, D. and Komba, E.V.G. 2020. Prevalence, risk factors, and antimicrobial resistance profiles of thermophilic Campylobacter species in humans and animals in Sub-Saharan Africa: a systematic review. Int. J. Microbiol. 2020(1), 2092478. Ghoneim, N.H., Sabry, M.A., Ahmed, Z.S. and Elshafiee, E.A. 2020. Campylobacter species isolated from chickens in Egypt: molecular epidemiology and antimicrobial resistance. Pakistan J. Zool. 52(3), 917–926. Grabowski, T., Gaffke, L., Pierzynowska, K., Cyske, Z., Choszcz, M., Węgrzyn,, G. and Węgrzyn,, A. 2022. Enrofloxacin-the ruthless killer of eukaryotic cells or the last hope in the fight against bacterial infections? Int. J. Mol. Sci. 23(7), 3648. Hemeg, H.A. 2018. Molecular characterization of antibiotic resistant Escherichia coli isolates recovered from food samples and outpatient clinics, KSA. Saudi J. Biol. Sci. 25(5), 928–931. Horrocks, S.M., Anderson, R.C., Nisbet, D.J. and Ricke, S.C. 2009. Incidence and ecology of Campylobacter jejuni and Campylobacter coli in animals. Anaerobe 15(1–2), 18–25. Igwaran, A. and Okoh, A.I. 2019. Human campylobacteriosis: a public health concern of global importance. Heliyon 5(11), e02814. Kate, M.T., William, A., Gary, C.B., Jackie, B., Joram, J.B., Sarah, C., Margaret, A.D., Nigel, P.F., Blandina, T.M., Gerard, P., Emmanuel, S.S., Ruth, N.Z. and John, A.C. 2020. Prevalence of Campylobacter and Salmonella in African food animals and meat: a systematic review and meta-analysis. Int. J. Food Microbiol. 315(1), 108382. Khairullah, A.R., Ramandinianto, S.C. and Effendi, M.H. 2020. A review of livestock-associated methicillin-resistant Staphylococcus aureus (LA-MRSA) on bovine mastitis. Syst. Rev. Pharm. 11(7), 172–183. Lee, J.H., Bae, I.K. and Lee, S.H. 2012. New definitions of extended-spectrum β-lactamase conferring worldwide emerging antibiotic resistance. Med. Res. Rev. 32(1), 216–232. Modi, S., Brahmbhatt, M.N., Chatur, Y.A. and Nayak, J.B. 2015. Prevalence of Campylobacter species in milk and milk products, their virulence gene profile and antibiogram. Vet. World 8(1), 1–8. Mpalang, R.K., Boreux, R., Melin, P., Akir Ni Bitiang, K.M.A., Daube, G. and De Mol, P. 2014. Prevalence of Campylobacter among goats and retail goat meat in Congo. J. Infect. Dev. Ctries. 8(2), 168–175. Mullner, P., Spencer, S.E.F., Wilson, D.J., Jones, G., Noble, A.D., Midwinter, A.C., Collins-Emerson, J.M., Carter, P., Hathaway, S. and French, N.P. 2009. Assigning the source of human Campylobacteriosis in New Zealand: a comparative genetic and epidemiological approach. Infect. Genet. Evol. 9(6), 1311–1319. Narvaez-Bravo, C., Taboada, E.N., Mutschall, S.K. and Aslam, M. 2017. Epidemiology of antimicrobial resistant Campylobacter spp. isolated from retail meats in Canada. Int. J. Food Microbiol. 253(1), 43–47. Okunlade, A.O., Ogunleye, A.O., Jeminlehin, F.O. and Ajuwape, A.T.P. 2015. Occurrence of Campylobacter species in beef cattle and local chickens and their antibiotic profiling in Ibadan, Oyo State, Nigeria. Afr. J. Microbiol. Res. 9(22), 1473–1479. Platts-Mills, J.A. and Kosek, M. 2014. Update on the burden of Campylobacter in developing countries. Curr. Opin. Infect. Dis. 27(5), 444–450. Portes, A.B., Panzenhagen, P., Dos Santos, A.M.P. and Junior, C.A.C. 2023. Antibiotic resistance in Campylobacter: a systematic review of south American isolates. Antibiotics (Basel) 12(3), 548. Premarathne, J.K., Anuar, A.S., Thung, T.Y., Satharasinghe, D.A., Jambari, N.N., Abdul-Mutalib, N.A., Huat, J.T.Y., Basri, D.F., Rukayadi, Y., Nakaguchi, Y., Nishibuchi, M. and Radu, S. 2017. Prevalence and antibiotic resistance against Tetracycline in Campylobacter jejuni and C. coli in cattle and beef meat from Selangor, Malaysia. Front. Microbiol. 8(1), 2254. Rapp, D., Ross, C.M., Pleydell, E.J. and Muirhead, R.W. 2012. Differences in the fecal concentrations and genetic diversities of Campylobacter jejuni populations among individual cows in two dairyherds. Appl. Environ. Microbiol. 78(21), 7564–7571. Singh, R., Singh, A.P., Kumar, S., Giri, B.S. and Kim, K.H. 2019. Antibiotic resistance in major rivers in the world: a systematic review on occurrence, emergence, and management strategies. J. Clean. Prod. 234(1), 1484–1505. Shen, Z., Wang, Y., Zhang, Q. and Shen, J. 2018. Antimicrobial resistance in Campylobacter sp. Microbiol. Spectr. 6(2), 10. Shnaiderman-Torban, A., Marchaim, D., Navon-Venezia, S., Lubrani, O., Paitan, Y., Arielly, H. and Steinman, A. 2021. Third generation cephalosporin resistant Enterobacterales infections in hospitalized horses and donkeys: a case-case-control analysis. Antibiotics (Basel) 10(2), 155. Tedersoo, T., Roasto, M., Mãesaar, M., Hãkkinen, L., Kisand, V., Ivanova, M., Valli, M.H. and Meremãe, K. 2022. Antibiotic resistance in Campylobacter spp. isolated from broiler chicken meat and human patients in Estonia. Microorganisms 10(5), 1067. Tyasningsih, W., Ramandinianto, S.C., Ansharieta, R., Witaningrum, A.M., Permatasari, D.A., Wardhana, D.K., Effendi, M.H. and Ugbo, E.N. 2022. Prevalence and antibiotic resistance of Staphylococcus aureus and Escherichia coli isolated from raw milk in East Java, Indonesia. Vet. World 15(8), 2021–2028. Ugbo, E.N., Jacob, J.I., Effendi, M.H., Witaningrum, A.M., Agumah, B.N., Ugbo, A.I. and Moses, B.I. 2023. Poultry slaughterhouses wastewater as reservoirs for spreading extended-spectrum beta-lactamase-producing Escherichia coli in Abakaliki, Nigeria. Biodiversitas 24(9), 4960–4966. Varga, C., Guerin, M.T., Brash, M.L., Siavic, D., Boerlin, P. and Susta, L. 2019. Antimicrobial resistance in Campylobacter jejuni and Campylobacter coli isolated from small poultry flocks in Ontario, Canada: a two-year surveillance study. PLoS One 14(8), e0221429. Verhoeff-Bakkenes, L., Jansen, H.A., in ”t Veld, P.H., Beumer, R.R., Zwietering, M.H. and van Leusden, F.M. 2011. Consumption of raw vegetables and fruits: a risk factor for Campylobacter infections. Int. J. Food Microbiol. 144(3), 406–412. Walther, B., Tedin, K. and Lãbke-Becker, A. 2017. Multidrug-resistant opportunistic pathogens challenging veterinary infection control. Vet. Microbiol. 200(1), 71–78. Wang, J., Seebacher, N., Shi, H., Kan, Q. and Duan, Z. 2017. Novel strategies to prevent the development of multidrug resistance (MDR) in cancer. Oncotarget 8(48), 84559–84571. Wibisono, F.J., Sumiarto, B., Untari, T., Effendi, M.H., Permatasari, D.A. and Witaningrum, A.M. 2021. Molecular identification of CTX gene of extended spectrum betalactamases (ESBL) producing Escherichia coli on layer chicken in Blitar, Indonesia. J. Anim. Plant. Sci. 31(4), 954–959. Wieczorek, K. and Osek, J. 2013. Antimicrobial resistance mechanisms among Campylobacter. Biomed. Res. Int. 2013(1), 340605. Wieczorek, K. and Osek, J. 2015. Poultry flocks as a source of Campylobacter contamination of broiler carcasses. Pol. J. Vet. Sci. 18(1), 101–106. Yanestria, S.M., Dameanti, F.N.A.E.P., Musayannah, B.G., Pratama, J.W.A., Witaningrum, A.M., Effendi, M.H. and Ugbo, E.N. 2022. Antibiotic resistance pattern of extended-spectrum β-lactamase (ESBL) producing Escherichia coli isolated from broiler farm environment in Pasuruan district, Indonesia. Biodiversitas 23(9), 4460–4465. Yanestria, S.M., Effendi, M.H., Tyasningsih, W., Khairullah, A.R., Kurniawan, S.C., Moses, I.B., Ikaratri, R., Samodra, M.E.E., Dameanti, E.P., Silaen, S.M., Mariyono, M. and Hasib, A. 2024. Fluoroquinolone resistance and phylogenetic analysis of broiler Campylobacter jejuni isolates in Indonesia. J. Adv. Vet. Res. 14(1), 204–208. Yanestria, S.M., Effendi, M.H., Tyasningsih, W., Mariyono, M. and Ugbo, E.N. 2023. First report of phenotypic and genotypic (blaOXA-61) beta-lactam resistance in Campylobacter jejuni from broilers in Indonesia. Vet. World 16(11), 2210–2216. | ||
| How to Cite this Article |
| Pubmed Style Agumah NB, Effendi MH, Tyasningsih W, Witaningrum AM, Ugbo EN, Agumah OB, Ahmad RZ, Nwagwu CS, Ugbo AI, Khairullah AR, Moses IB, Yanestria SM, Riwu KHP, Wasito W. Distribution of cephalosporin-resistant Campylobacter species isolated from meat sold in Abakaliki, Nigeria. Open Vet. J.. 2025; 15(4): 1615-1623. doi:10.5455/OVJ.2025.v15.i4.13 Web Style Agumah NB, Effendi MH, Tyasningsih W, Witaningrum AM, Ugbo EN, Agumah OB, Ahmad RZ, Nwagwu CS, Ugbo AI, Khairullah AR, Moses IB, Yanestria SM, Riwu KHP, Wasito W. Distribution of cephalosporin-resistant Campylobacter species isolated from meat sold in Abakaliki, Nigeria. https://www.openveterinaryjournal.com/?mno=231143 [Access: January 25, 2026]. doi:10.5455/OVJ.2025.v15.i4.13 AMA (American Medical Association) Style Agumah NB, Effendi MH, Tyasningsih W, Witaningrum AM, Ugbo EN, Agumah OB, Ahmad RZ, Nwagwu CS, Ugbo AI, Khairullah AR, Moses IB, Yanestria SM, Riwu KHP, Wasito W. Distribution of cephalosporin-resistant Campylobacter species isolated from meat sold in Abakaliki, Nigeria. Open Vet. J.. 2025; 15(4): 1615-1623. doi:10.5455/OVJ.2025.v15.i4.13 Vancouver/ICMJE Style Agumah NB, Effendi MH, Tyasningsih W, Witaningrum AM, Ugbo EN, Agumah OB, Ahmad RZ, Nwagwu CS, Ugbo AI, Khairullah AR, Moses IB, Yanestria SM, Riwu KHP, Wasito W. Distribution of cephalosporin-resistant Campylobacter species isolated from meat sold in Abakaliki, Nigeria. Open Vet. J.. (2025), [cited January 25, 2026]; 15(4): 1615-1623. doi:10.5455/OVJ.2025.v15.i4.13 Harvard Style Agumah, N. B., Effendi, . M. H., Tyasningsih, . W., Witaningrum, . A. M., Ugbo, . E. N., Agumah, . O. B., Ahmad, . R. Z., Nwagwu, . C. S., Ugbo, . A. I., Khairullah, . A. R., Moses, . I. B., Yanestria, . S. M., Riwu, . K. H. P. & Wasito, . W. (2025) Distribution of cephalosporin-resistant Campylobacter species isolated from meat sold in Abakaliki, Nigeria. Open Vet. J., 15 (4), 1615-1623. doi:10.5455/OVJ.2025.v15.i4.13 Turabian Style Agumah, Nnabuife Bernard, Mustofa Helmi Effendi, Wiwiek Tyasningsih, Adiana Mutamsari Witaningrum, Emmanuel Nnabuike Ugbo, Onyinyechi Blessing Agumah, Riza Zainuddin Ahmad, Chinekwu Sherridan Nwagwu, Agatha Ifunanya Ugbo, Aswin Rafif Khairullah, Ikechukwu Benjamin Moses, Sheila Marty Yanestria, Katty Hendriana Priscilia Riwu, and Wasito Wasito. 2025. Distribution of cephalosporin-resistant Campylobacter species isolated from meat sold in Abakaliki, Nigeria. Open Veterinary Journal, 15 (4), 1615-1623. doi:10.5455/OVJ.2025.v15.i4.13 Chicago Style Agumah, Nnabuife Bernard, Mustofa Helmi Effendi, Wiwiek Tyasningsih, Adiana Mutamsari Witaningrum, Emmanuel Nnabuike Ugbo, Onyinyechi Blessing Agumah, Riza Zainuddin Ahmad, Chinekwu Sherridan Nwagwu, Agatha Ifunanya Ugbo, Aswin Rafif Khairullah, Ikechukwu Benjamin Moses, Sheila Marty Yanestria, Katty Hendriana Priscilia Riwu, and Wasito Wasito. "Distribution of cephalosporin-resistant Campylobacter species isolated from meat sold in Abakaliki, Nigeria." Open Veterinary Journal 15 (2025), 1615-1623. doi:10.5455/OVJ.2025.v15.i4.13 MLA (The Modern Language Association) Style Agumah, Nnabuife Bernard, Mustofa Helmi Effendi, Wiwiek Tyasningsih, Adiana Mutamsari Witaningrum, Emmanuel Nnabuike Ugbo, Onyinyechi Blessing Agumah, Riza Zainuddin Ahmad, Chinekwu Sherridan Nwagwu, Agatha Ifunanya Ugbo, Aswin Rafif Khairullah, Ikechukwu Benjamin Moses, Sheila Marty Yanestria, Katty Hendriana Priscilia Riwu, and Wasito Wasito. "Distribution of cephalosporin-resistant Campylobacter species isolated from meat sold in Abakaliki, Nigeria." Open Veterinary Journal 15.4 (2025), 1615-1623. Print. doi:10.5455/OVJ.2025.v15.i4.13 APA (American Psychological Association) Style Agumah, N. B., Effendi, . M. H., Tyasningsih, . W., Witaningrum, . A. M., Ugbo, . E. N., Agumah, . O. B., Ahmad, . R. Z., Nwagwu, . C. S., Ugbo, . A. I., Khairullah, . A. R., Moses, . I. B., Yanestria, . S. M., Riwu, . K. H. P. & Wasito, . W. (2025) Distribution of cephalosporin-resistant Campylobacter species isolated from meat sold in Abakaliki, Nigeria. Open Veterinary Journal, 15 (4), 1615-1623. doi:10.5455/OVJ.2025.v15.i4.13 |